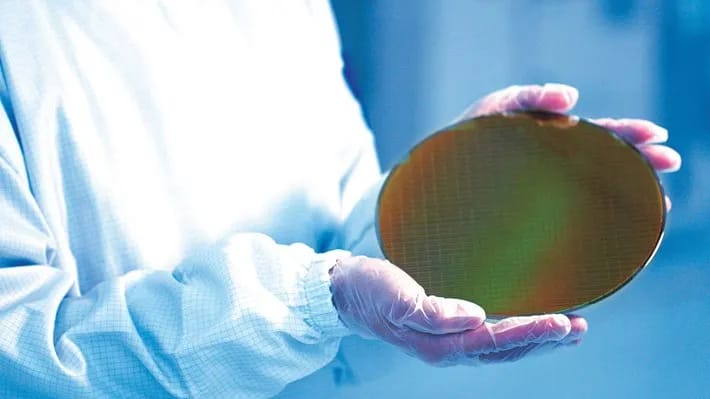

"Samsung Electronics" Yaponiyanın "Preferred Networks" şəbəkələri üçün 2nm çiplər istehsal etməyə başlayır. Bu, "Samsung"un ilk 2nm sifarişi olsa da, Yapon şirkətinin TSMC-dən imtina etdiyi bildirilir.
7NEWS.az xəbər verir ki, "Samsung" və TSMC arasında növbəti onilliyə təsir edə biləcək müharibə gedir. Yeni nəsil istehsal proseslərində geridə qalmaq istəməyən hər iki tökmə nəhəngi yeni nəsil litoqrafiyalarını inkişaf etdirməyə davam edir. Bir müddət əvvəl sizə əhəmiyyətli bir müştəri olan "Qualcomm"un hər iki şirkətdən 2nm nümunələr tələb etdiyini söylədik. Ancaq indi Yapon "Preferred Networks" (PFN) birbaşa "Samsung"un ilk 2nm müştərisi oldu.
7NEWS.az